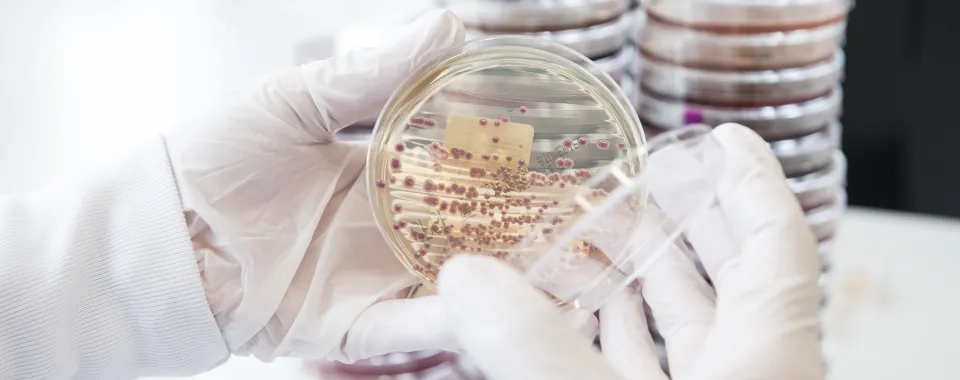
Image d'entérobactéries - HUG

Deux méta-analyses menées par les Hôpitaux universitaires de Genève (HUG) et l’Université de Genève (UNIGE) révèlent un taux très inquiétant d’enfants porteurs de souches bactériennes multirésistantes, en Afrique subsaharienne. Les analyses se sont focalisées sur les entérobactéries, bactéries responsables de la majorité des infections invasives chez les nouveau-nés de cette région. La première montre que 41 % des bactéries Escherichia coli et 85 % des Klebsiella spp trouvées dans le sang des enfants lors d’infections sont résistantes aux traitements utilisés habituellement dans les cas d’infections sévères de l’enfant. La seconde révèle qu’un tiers des enfants sont colonisés par des entérobactéries résistantes aux céphalosporines. Or, il n’y a souvent pas d’autres options thérapeutiques disponibles dans cette région en cas d’échec de ce traitement. Les deux études sont à découvrir dans le journal eClinicalMedicine publié dans The Lancet1 .
La résistance aux antibiotiques est une préoccupation majeure pour la santé mondiale. Le problème est particulièrement vif dans les pays d’Afrique subsaharienne qui affichent le taux le plus élevé de décès attribué à la résistance aux antibiotiques, notamment dans l’ouest de la région, où il dépasse 100 décès pour 100 000 personnes. Les enfants et les nouveau-nés sont particulièrement exposés. Ainsi, 30 % des nouveau-nés atteints de septicémie (sepsis), une réaction inflammatoire grave à la suite d’une infection, décèdent à cause de résistances aux antibiotiques.
Malgré cette situation, peu de données épidémiologiques existent sur l’incidence de ce fléau chez les enfants. Elles sont pourtant cruciales pour développer des recommandations de traitement appropriées. C’est pourquoi une équipe des HUG, menée par la Dre Noémie Wagner, médecin adjointe agrégée, à l’Unité d’infectiologie pédiatrique des HUG et privat-docent au Département de pédiatrie, gynécologie et obstétrique de la Faculté de médecine de l’UNIGE, et la Pre Annick Galetto-Lacour, médecin adjointe agrégée au Service d’accueil et d’urgences pédiatriques des HUG et professeure associée au Département de pédiatrie, gynécologie et obstétrique de la Faculté de médecine de l’UNIGE, a mené deux méta-analyses.
Présence massive d’entérobactéries résistantes lors d’infections sévères
La première étude visait à évaluer la proportion d’entérobactéries résistantes aux antibiotiques chez les enfants en Afrique subsaharienne lors d’infections. Ces bactéries, très fréquemment retrouvées dans les infections sévères, sont connues pour leur capacité à développer des résistances aux antibiotiques.
L’équipe de recherche a tout d’abord effectué une revue systématique de 1 111 études publiées entre 2005 et 2022 concernant des enfants présentant une infection. Elle en a retenu 122, puis a extrait les données publiées de plus de 30 000 échantillons de sang, d’urine et de selles d’enfants âgés de 0 à 18 ans, afin de réaliser une méta-analyse.
« Nous avons observé une forte proportion de bactéries résistantes aux antibiotiques, notamment pour celles trouvées dans le sang des jeunes patients et patientes », indique la Dre Noémie Wagner. Les espèces les plus fréquentes sont l’Escherichia coli (E. coli) et les Klebsiella spp. L’étude a pu mettre en évidence leur résistance significative aux antibiotiques. L’équipe de recherche a observé des proportions élevées de résistance à l’ampicilline et à la gentamicine, qui sont les antibiotiques recommandés en première intention dans les sepsis. Pour E. coli, ils atteignaient ainsi 92,5 % pour l’ampicilline et 42,7% pour la gentamicine. Les souches de Klebsiella spp, toujours résistantes à l’ampicilline, présentaient des proportions de résistance de 77,6 % à la gentamicine. Les entérobactéries analysées montraient également des proportions élevées de résistance aux céphalosporines de troisième génération, qui représentent la 2e ligne de traitement du sepsis de l’enfant, avec respectivement 40,6 % des échantillons d’E. coli et 84,9 % des échantillons de Klebsiella spp résistants. Ces résultats suggèrent donc une proportion très élevée de résistance aux antibiotiques recommandés en première et deuxième lignes pour les sepsis de l’enfant.
Trop d’enfants porteurs
La seconde étude a cherché à estimer, toujours à travers une revue systématique d’études et une méta-analyse, la prévalence du nombre d’enfants colonisés par des entérobactéries résistantes aux céphalosporines de 3ème génération. Le terme colonisation désigne le fait de retrouver des bactéries dans les selles d’un enfant, sans infection existante.
40 études sur les 1 111 ont été retenues, représentant une cohorte de 9 408 enfants, soit la plus large connue à ce jour pour l’Afrique subsaharienne. Il en résulte que 32,2% des enfants sont porteurs d’entérobactéries résistantes aux céphalosporines à large spectre. « Ces proportions sont très élevées et inquiétantes. En effet, ces traitements sont donnés en deuxième ligne lorsque ceux de première ligne ont échoué. Or, il n’y a souvent pas d’autres options thérapeutiques disponibles dans cette région en cas d’échec » réagit la Pre Annick Galetto-Lacour.
L’étude révèle également que 53,8 % des enfants entrés à l’hôpital sans être porteurs d’entérobactéries résistantes sont ressortis positifs pour ces bactéries.
Ce travail démontre, enfin, que le risque d’être porteur d’une entérobactérie multirésistante est trois fois plus élevé après avoir reçu un traitement antibiotique trois mois auparavant. Or, en Afrique subsaharienne, entre 83 % et 100 % des enfants hospitalisés sont traités avec des antibiotiques. « Comme les infections bactériennes sont la principale cause des décès dans cette région, les enfants sont très fréquemment traités par antibiotiques dès leur admission à l’hôpital, même en l’absence d’argument solide pour suspecter une infection bactérienne. En Afrique subsaharienne, la majorité des structures médicales n’a pas accès aux marqueurs inflammatoires qui peuvent aider à distinguer une infection bactérienne, nécessitant des antibiotiques, d’une infection virale. Elles n’ont pas non plus la possibilité de réaliser des cultures et ne peuvent donc ni identifier correctement les espèces bactériennes, ni réaliser des tests de susceptibilité antimicrobienne. C’est le serpent qui se mord la queue, car l’usage abusif des antibiotiques augmente la proportion de bactéries résistantes qui vont être plus difficiles à traiter », s’inquiète la Dre Noémie Wagner.
Une situation alarmante
Ces chiffres très élevés sont alarmants, car ils sont notamment largement supérieurs aux estimations faites dans le passé. Ils soulignent l’urgente nécessité d’actions ciblées pour gérer et réguler la résistance aux antibiotiques en Afrique subsaharienne.
« Réduire l’antibiorésistance nécessite de travailler sur plusieurs axes. D’une part, renforcer toutes les mesures visant à une utilisation appropriée des antibiotiques et, d’autre part, limiter la transmission des infections grâce aux mesures d’hygiène. Un meilleur accès aux examens complémentaires (marqueurs inflammatoires et analyses bactériologiques) est nécessaire afin de diminuer l’utilisation systématique d’antibiotiques, d’adapter les traitements aux bactéries retrouvées et d’ajuster les recommandations de traitement au profil de résistance des bactéries circulant dans la région. Dans ce contexte, le développement par Médecins sans frontières de «Mini-lab », est particulièrement intéressant. Il s’agit de laboratoires de bactériologie clinique, tout-en-un, autonomes, transportables et à un coût abordable. Enfin, il est nécessaire de mener d’autres études prospectives, provenant notamment de zones plus reculées », conclut la Dre Noémie Wagner.
Pour aller plus loin, consultez un article paru dans Scientific reports, présentant une nouvelle application qui permet de classer les antibiotiques en fonction de leur spectre d’activité.
Lire le communiqué en anglais.
HUG, Service de presse et relations publiques
presse-hug@hug.ch
+41 22 372 37 37
UNIGE, Service des médias
media@unige.ch
+41 22 379 77 96